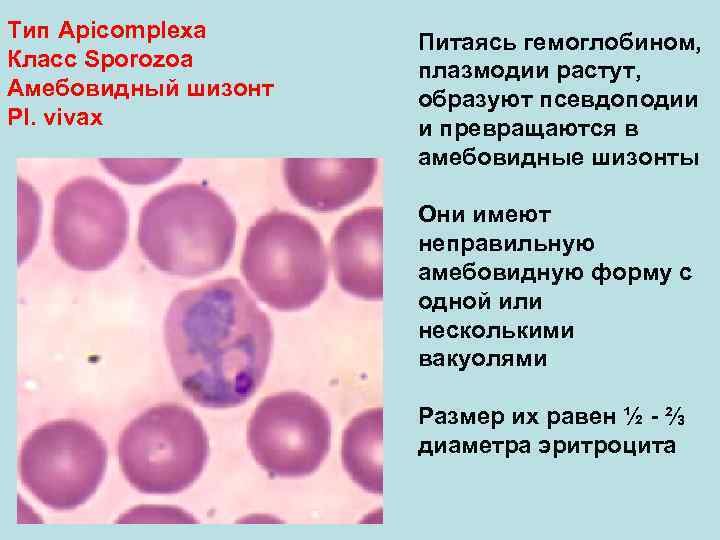
Тип Аpicomplexa Питаясь гемоглобином, Класс Sporozoa  плазмодии растут, Амебовидный шизонт  образуют псевдоподии

План лекции •

План лекции • Общая характеристика царства Протисты. 2. Паразитические саркодовые: дизентерийная, кишечная и ротовая амебы. Особенности жизненного цикла дизентерийной амебы, патогенное действие; симптомы, диагностика и профилактика амебиаза. 3. Амебы группы Limax: способы заражения человека, патогенное действие. 4. Паразитические жгутиковые: лейшмании, трипаносомы, лямблия и трихомонады, особенности их строения и размножения, способы заражения человека, патогенное действие; симптомы, диагностика и профилактика вызываемых ими заболеваний.
1. Общая характеристика Простейших • Простейшие (протисты) – это одноклеточные организмы, тело которых состоит из цитоплазмы и одного или нескольких ядер. Клетка простейшего – это самостоятельная особь, проявляющая все основные свойства живой материи. Она выполняет функции всего организма, тогда как клетки многоклеточных составляют лишь часть организма, каждая клетка зависит от многих других. • Большинство простейших имеют микроскопические размеры – 3— 150 мкм, но есть крупные представители вида (раковинные корненожки) достигают 2– 3 см в диаметре.
• Строение тела простейшего типично для эукариотической клетки. Имеются органеллы общего (митохондрии, рибосомы, клеточный центр, ЭПС и др. ) и специального назначения (Органы движения: ложноножки, или псевдоподии (временные выросты цитоплазмы), жгутики, реснички, пищеварительные и сократительные вакуоли). Органоиды пищеварения – пищеварительные вакуоли с пищеварительными ферментами (сходны по происхождению с лизосомами). Питание происходит путем пино– или фагоцитоза. Непереваренные остатки выбрасываются наружу. Некоторые простейшие имеют хлоропласты и питаются за счет фотосинтеза. Пресноводные простейшие имеют органы осморегуляции – сократительные вакуоли, которые периодически выделяют во внешнюю среду излишки жидкости и продукты диссимиляции. Большинство простейших имеет одно ядро, но есть представители с несколькими ядрами. Ядра некоторых простейших характеризуются полиплоидностью. Цитоплазма неоднородна. Она подразделяется на более светлый и гомогенный наружный слой, или эктоплазму, и зернистый внутренний слой, или эндоплазму. Наружные покровы представлены либо цитоплазматической мембраной (у амебы), либо пелликулой (у эвглены).
2. Паразитические саркодовые: дизентерийная, кишечная и ротовая амебы. Особенности жизненного цикла дизентерийной амебы, патогенное действие; симптомы, диагностика и профилактика амебиаза. • ДИЗЕНТЕРИЙНАЯ АМЕБА, Entamoeba histolytica – возбудитель амебиаза (амебной дизентерии). Заболевание распространено повсеместно, чаще встречается в странах с жарким климатом. • Морфологические особенности: есть 2 стадии – вегетативная (трофозоит) и циста. Цисты (размеры 8 -16 мкм) содержат 4 ядра. Трофозоиты существуют в 3 -х формах: малой вегетативной (forma minuta), большой вегетативной (forma magna) и тканевой. Малые вегетативные формы (диаметр 12 -20 мкм) способны к передвижению, питаются бактериями. Эта форма непатогенна. Большая вегетативная форма (размеры 30 -40 мкм) заглатывает эритроциты, выделяет протеолитические ферменты. Тканевая форма (размеры 20 -25 мкм) способна быстро двигаться с помощью псевдоподий. Большая вегетативная и тканевая формы патогенны.
Жизненный цикл: заражение человека происходит через рот (алиментарно) при проглатывании цист. Факторами передачи цист могут быть загрязненные овощи, фрукты и вода. Механические переносчики цист – мухи и тараканы. Из цисты в просвете кишечника образуются 4 малые вегетативные формы. Они могут длительно существовать и превращаться в цисты (цистоносительство). При ослаблении организма хозяина малая вегетативная форма может переходить в большую вегетативную форму. Такому превращению способствуют ряд факторов: нарушение функции пищеварительной системы (потребление острой пищи, голодание), ослабление организма хозяина перенесенными инфекциями, переохлаждение и др. Большая вегетативная форма разрушает эпителий слизистой толстого кишечника. В стенке кишечника большая вегетативная форма превращается в тканевую и по кровеносным сосудам может попадать в печень, мозг и другие органы, вызывая воспалительные процессы. При затухании болезни патогенные формы в просвете кишечника превращаются в малые вегетативные, а затем – в цисты.
Патогенное действие. • Механическое (разрушение слизистой толстого кишечника с образованием кровоточащих язв диаметром от нескольких миллиметров до 2 -2, 5 см). • Токсико-аллергическое (отравление организма продуктами жизнедеятельности). • Питание за счет организма хозяина и нарушение обменных процессов (поглощение эритроцитов и витаминов, нарушение водно-солевого обмена).
• Характерные симптомы: кровавая диарея (понос) до 10 -и и более раз в сутки. Пациентов беспокоят боли в животе по ходу начального отдела толстого кишечника п(равая подвздошная область). Выраженность интоксикации может быть разной степени. • Осложнения амебиаза: амебные абсцессы печени и легких, гнойные перитониты, воспалительные процессы кожи промежности. • Лабораторная диагностика: микроскопическое исследование мазков фекалий, содержимого из дна язв и нахождение в них тканевой и большой вегетативной форм. Обнаружение цист в фекалиях возможно при затухании заболевания и цистоносительстве. • Профилактика: личная – соблюдение правил гигиены (чистота рук, мытье горячей водой овощей и фруктов, защита продуктов питания от мух и тараканов и т. п. ). Общественная профилактика: выявление и лечение больных амебиазом; контроль за санитарным состоянием водоисточников, пищевых предприятий, продовольственных магазинов и рынков; обследование на цистоносительство работников предприятий общественного питания; уничтожение мух и тараканов; санитарно-просветительная работа.
3. АМЕБЫ ГРУППЫ LIMAX. К ним относятся свободноживущие амебы, обитающие в естественных и искусственных водоемах и почве. Попадая в организм человека, они способны вызывать тяжелые воспалительные процессы ЦНС (менингоэнцефалиты). Наиболее опасны представители двух родов: Naegleria и Acanthamoeba. • Морфологические особенности: вегетативные формы рода Naegleria (размер 20 -30 мкм) имеют короткие широкие псевдоподии (амебоидная стадия). При резком изменении температуры и других факторов среды амебы образуют 2 жгутика (жгутиковая стадия) и переходят к активному движению. При наступлении неблагоприятных условий амебы инцистируются. Размеры цист 8 -16 мкм. У представителей рода Acanthamoeba жгутиковой стадии нет. Амебоидные формы имеют многочисленные узкие, заостренные псевдоподии. Размеры цист 12 -15 мкм. Цисты могут образовываться в тканях.
• Жизненный цикл: амебы группы Limax могут паразитировать у человека, обезьян и грызунов. Наиболее вирулентна Naegleria. Заражение человека происходит через слизистую носоглотки при купании в открытых водоемах и бассейнах, через воду при умывании (Naegleria), цистами с пылью (Acanthamoeba). В носовой полости амебы размножаются и по ходу обонятельного нерва проникают в головной мозг. Патогенное действие: • Механическое (разрушают серое вещество больших полушарий головного мозга и его оболочки); • Токсико-аллергическое (отравление организма продуктами жизнедеятельности) • Вследствие нарушения целостности клеток и оболочек мозга развиваются воспалительные процессы – менингоэнцефалит. • Инкубационный период длится 4 -7 дней.
• Характерные симптомы: насморк, недомогание, конъюнктивит, кашель, повышение температуры. Затем появляются симптомы поражения оболочек и вещества головного мозга (высокая температура, рвота, потеря сознания и др. ), которые постепенно нарастают и часто при отсутствии лечения через 3 -5 дней наступает смертельный исход. • Лабораторная диагностика: обнаружение вегетативных форм в спинно-мозговой жидкости (ликворе). • Профилактика – не купаться в открытых водоемах, санитарный контроль за состоянием воды, санитарно- просветительная работа.
4. Паразитические жгутиковые: Тип Sarcomastigophora Класс Zoomastigota Leischmania donovani – возбудитель общего (висцерального) лейшманиоза, Leischmania tropica – кожного лейшманиоза, а Leischmania brasiliensis – кожно- слизистого лейшманиоза. Лейшманиозы – трансмиссивные природно-очаговые заболевания. Висцеральный лейшманиоз распространен в странах Средиземноморья, Средней и Южной Азии, Африки и Южной Америки. Кожный лейшманиоз встречается в странах Южной Европы, Северной и Западной Африки, Ближнего Востока, Центральной и Южной Азии. Основной очаг кожно-слизистого лейшманиоза находится в Южной и Центральной Америке. Морфологические особенности: Есть 2 формы – промастигота (имеет жгутик, отходящий от кинетопласта и размеры до 10 -20 мкм) амастигота (безжгутиковая округлая или овальная форма,
Жизненный цикл: специфическими переносчиками лейшманий являются москиты, у которых паразиты размножаются в пищеварительном тракте и накапливаются в хоботке. В организме переносчика образуется жгутиковая стадия – промастигота. Заражение человека происходит при укусах москитом (трансмиссивный путь). В организме человека и других позвоночных (рептилии, млекопитающие) лейшмании теряют жгутик, превращаются в амастиготы, переходят к внутриклеточному паразитированию и интенсивно размножаются. Природными резервуарами L. donovani могут быть шакалы, собаки, грызуны, L. tropica – грызуны, L. braziliensis – грызуны, обезьяны, ленивцы.
Патогенное действие: Механическое (разрушение клеток печени, селезенки, лимфатических узлов, красного костного мозга). Токсико-аллергическое (отравление организма продуктами жизнедеятельности). • Инкубационный период длится от нескольких недель до 6 -8 месяцев. Характерные симптомы: лихорадка неправильного типа, слабость, головная боль, интоксикация, истощение, пигментация кожи, сыпь, увеличение печени и селезенки, анемия. Болеют висцеральным лейшманиозом чаще дети. Перенесенные лейшманиозы дают стойкий иммунитет. Лабораторная диагностика: обнаружение лейшманий в пунктатах костного мозга (грудина), лимфатических узлов, иногда печени или селезенки. Применяются иммунологические методы исследований (определение антител в сыворотке крови больных).
Тип Sarcomastigophora Класс Zoomastigota Trypanosoma brucei ТРИПАНОСОМЫ являются возбудителями африканской сонной болезни (африканский трипаносомоз) В цикле развития трипаносом существует следующие стадии: - трипомастигота имеет удлиненную форму, длинный жгутик, ундулирующую мембрану, подвижна; паразитирует в организме позвоночных хозяев (человек и животные) и является для них инвазионной стадией; - эпимастигота похожа на трипомастиготу, но ее жгутик более короткий и ундулирующая мембрана выражена слабо; существует только в организме переносчика и способна превращаться в трипомастиготу; - амастигота неподвижна, так как отсутствует и жгутик и ундулирующая мембрана, паразитирует в организме позвоночных хозяев, внутриклеточный паразит; способна превращаться в трипомастиготу. Тело изогнутое, сплющенное в одной плоскости, сужено на обоих концах, имеет жгутик, который идет по краю ундулирующей мембраны. У основания жгутика имеется кинетопласт. Длина тела трипаносом 13 -40 мкм, ширина – 1, 5 -2 мкм. Питаются осмотически. Размножаются продольным делением надвое.
• Локализация трипаносом – спинномозговая жидкость, откуда они попадают в головной и спинной мозг. • Патогенное действие: Механическое (разрушение клеток и тканей пораженных органов). Токсико-аллергическое (отравление организма продуктами жизнедеятельности). Инкубационный период продолжается от 1 -ой недели до 2 лет. • Характерные симптомы: трипаносомозный шанкр в месте укуса мухи (очаг воспаления около 10 см в диаметре), увеличение лимфатических узлов на задней поверхности шеи, повышение температуры, слабость, истощение. Позже появляются симптомы поражения ЦНС: сонливость, прогрессирующее слабоумие, сопорозное (заторможенное), а затем коматозное состояние (потеря сознания). • Лабораторная диагностика: обнаружение трипаносом в мазках крови, спинномозговой жидкости, пунктатах лимфатических узлов, селезенки, костного мозга. Используются иммунологические реакции (определение антител в сыворотке крови больных). • Профилактика: выявление и лечение больных, уничтожение и защита от укусов поцелуйных клопов (отпугивающие средства и др. ), санитарно-просветительная работа.
Тип Sarcomastigophora Класс Zoomastigota Lamblia intestinalis – возбудитель лямблиоза. Паразитирует только у человека. Заболевание распространено повсеместно. Грушевидная форма с заостренным задним концом Размер – 10 -18 мкм, 4 пары жгутиков 2 опорных стержня (аксостили), 2 симметричные половины, имеющие по 1 ядру и присасывательному диску. Питание осмотическое, размножение бесполое (продольное деление надвое). Цисты овальной или округлой формы, размером 10 -14 мкм.
Жизненный цикл: имеются 2 стадии: вегетативная (трофозоит) и циста. Заражение происходит алиментарным путем при заглатывании цист лямблий с немытыми овощами и фруктами, с водой. Эксцистирование происходит в двенадцатиперстной кишке. Обитает лямблия в верхнем отделе тонкого кишечника и в желчных ходах. Патогенное действие. • Механическое (раздражение слизистой двенадцатиперстной кишки, нарушение пристеночного пищеварения и всасывания, особенно жиров и жирорастворимых витаминов). • Токсико-аллергическое (отравление организма продуктами жизнедеятельности). • Питание за счет организма хозяина и нарушение обменных процессов (поглощение питательных веществ и витаминов). Лямблиоз отягощает течение других заболеваний пищеварительной системы.
• Характерные симптомы: общее недомогание, снижение аппетита, тошнота, боли в эпигастральной области и в правом подреберье, неустойчивый стул (поносы, запоры). Лямблии часто встречаются у совершенно здоровых людей. • Лабораторная диагностика: обнаружение вегетативных форм (трофозоитов) в фекалиях или в дуоденальном содержимом. • Профилактика: соблюдение правил личной гигиены, выявление и лечение больных, санитарно-просветительная работа.
Тип Sarcomastigophora Класс Zoomastigota Trichomonas vaginalis – возбудитель урогенитального трихомоноза. Заболевание распространено повсеместно. Тело овальной формы с заостренным длинным шипом на заднем конце. Размеры до 30 мкм. Имеет 5 жгутиков. Один жгутик идет вдоль ундулирующей мембраны. По середине тела проходит опорный стержень (аксостиль). В цитоплазме расположено ядро и пищеварительные вакуоли.
• Жизненный цикл: заражение происходит при половых контактах, возможно заражение через нестерильный гинекологический инструментарий и перчатки. Поражает мочеполовые пути, вызывая воспалительные процессы. Цист не образует. • Патогенное действие. • Механическое (разрушение слизистой мочеполовых путей). • Токсико-аллергическое (отравление организма продуктами жизнедеятельности). • Характерные симптомы: при остром течении наблюдаются зуд, жжение в мочеполовых путях, местный воспалительный процесс, обильные жидкие выделения зеленоватого цвета с неприятным запахом. Иногда возможны осложнения в виде уретрита и простатита у мужчин.
• Лабораторная диагностика: обнаружение трофозоитов в мазках содержимого из мочеполовых путей. • Профилактика: выявление и лечение больных, исключение случайных половых контактов, стерильность инструментов смотровых кабинетов, санитарно- просветительная работа.
Тип Infusoria Класс Ciliata Тело овальной Balantidium coli – или яйцевидной единственный паразит формы; человека из класса размеры Ресничные, вызывает 30 -150 х 40 -70 балантидиаз (инфузорную дизентерию). Заболевание мкм На заднем конце распространено тела – повсеместно. порошица Макронуклеус бобовидной формы Две сократительные вакуоли Есть перистом, переходящий в цитостом и воронкообразн ый цитофарингс
• Цикл развития: вегетативная форма паразитирует в толстом отделе кишечника, преимущественно в слепой кишке. Заражение человека происходит алиментарным путем при проглатывании цист с загрязненными овощами, фруктами, питьевой водой. Инвазионной стадией является циста. Чаще балантидиазом болеют работники свиноферм, так как свиньи являются источником инвазии. В пищеварительном тракте из цист образуются трофозоиты. В нижних отделах кишечника трофозоиты инцистируются и выделяются с фекалиями наружу. • Патогенное действие. • Механическое (повреждение слизистой оболочки кишечника и образование глубоких язв). • Токсико-аллергическое (отравление организма продуктами жизнедеятельности). • Питание за счет организма хозяина (балантидий питается пищевыми частицами, иногда в его цитоплазме находят эритроциты и лейкоциты).
• Характерные симптомы: кровавый понос, боли в животе, рвота, недомогание, слабость, головная боль. • Осложнения: прободение язв и абсцессы печени. • Лабораторная диагностика: обнаружение в мазках фекалий вегетативных форм паразита. • Профилактика: соблюдение правил личной гигиены, выявление и лечение больных. Охрана окружающей среды от загрязнений фекалиями свиней и больных людей, санитарно-просветительная работа.
Тип Аpicomplexa Класс Sporozoa Toxoplasma gondii – представитель класса Споровики, отряда Кокцидии. Она является возбудителем токсоплазмоза. Заболевание распространено повсеместно. Имеет полулунную форму Размеры 4 -7 х 2 -4 мкм Ядро крупное На заостренном конце есть коноид
Тип Аpicomplexa Плазмодий имеет вид Класс Sporozoa кольца или перстня − Кольцевидный шизонт его бόльшая, Pl. vivax центральная часть занята крупной вакуолью, которая оттесняет ядро к периферии клетки На этой стадии плазмодий занимает около ⅓ объема эритроцита Может быть 2 -3 кольца в одном эритроците
Тип Аpicomplexa Питаясь гемоглобином, Класс Sporozoa плазмодии растут, Амебовидный шизонт образуют псевдоподии Pl. vivax и превращаются в амебовидные шизонты Они имеют неправильную амебовидную форму с одной или несколькими вакуолями Размер их равен ½ - ⅔ диаметра эритроцита
Тип Аpicomplexa Класс Sporozoa Морула Pl. vivax Ядро шизонта многократно делится (на 6 -24 части), вокруг ядер обособляются участки цитоплазмы – образуется морула
Гаметоцит занимает весь Тип Аpicomplexa объем увеличенного Класс Sporozoa эритроцита Гаметоцит Pl. vivax Он имеет небольшое, интенсивно окрашенное в рубиновый цвет, ядро, расположенное на периферии клетки В темно-голубой протоплазме равномерно рассеяны почти черные палочковидные частицы пигмента Гаметоцит похож на крупный шизонт
Тип Plathelminthes Форма Класс Trematoda листовидная, Fasciola hepatica 3 -5 см На передней части тела расположены 2 присоски – ротовая и брюшная Каналы За брюшной присоской расположена кишечника многолопастная матка сильно под ней – яичник разветвлены по бокам тела – многочисленные желточники среднюю часть занимают ветвящиеся семенники
Тип Plathelminthes Класс Trematoda Fasciola hepatica Яйца крупные (135 х80 мкм), овальные, желтовато- коричневые, на одном из полюсов имеется крышечка
Тип Plathelminthes Цвет бледно- Класс Trematoda желтый, длиной Opisthorchis felineus около 10 мм В средней части расположена матка, за ней – округлый яичник и бобовидный семяприемник В задней части тела – 2 розетковидных семенника, между ними S-образно изогнутый канал выделительной системы Кишечник не ветвятся; между ним и краем тела расположены желточники
Тип Plathelminthes Класс Trematoda Opisthorchis felineus Яйца размером 26 -30 х10 -15 мкм, желтовато- коричневого цвета, овальные, слегка суженные к одному полюсу, на котором имеется крышечка
Тип Plathelminthes Класс Trematoda Яйцо размером 120 Schistosoma haematobium -190 х50 -73 мкм Форма веретенообразная, без крышечки Острый шип на одном полюсе расположен вдоль продольной оси яйца Оболочка тонкая, прозрачная
Тип Plathelminthes Класс Cestoda Taenia solium Сколекс имеет четыре присоски и хоботок, вооруженный двумя рядами крючьев
Тип Plathelminthes Класс Cestoda Taenia solium Гермафродитная проглоттида содержит трехдольчатый яичник (третья дополнительная долька яичника расположена между маткой и влагалищем)
Тип Plathelminthes Класс Cestoda Taenia solium Зрелая проглоттида содержит матку с 7 -12 боковыми ответвлениями с каждой стороны
Тип Plathelminthes Класс Cestoda Taeniarhynchus saginatus На сколексе расположены 4 присоски − невооруженный
Тип Plathelminthes Класс Cestoda Гермафродитные Taeniarhynchus saginatus проглоттиды имеют двухдольчатый яичник Под яичником расположены желточники Половая клоака открывается на боковой стороне проглоттиды
Тип Plathelminthes Класс Cestoda Taeniarhynchus saginatus В зрелых члениках матка содержит 17 -35 боковых ответвлений с каждой стороны в матке находится до 175 000 яиц
Тип Plathelminthes Класс Cestoda Taenia solium и Taeniarhynchus saginatus Размеры 30 -40 х20 -30 мкм Форма округлая, реже слегка овальная Оболочка толстая, двухконтурная, поперечно -исчерченная, прозрачная Внутри расположена онкосфера
Тип Plathelminthes Длина от 1 до 5 см, Класс Cestoda содержит около Hymenolepis nana 200 проглоттид На сколексе расположены 4 присоски и хоботок с двойным венчиком крючьев Матка закрытая, но тонкая, стенка проглоттид легко разрушается
Тип Plathelminthes Класс Cestoda Diphyllobothrium latum На сколексе есть две присасывательные щели – ботрии, которыми паразит прикрепляется к слизистой оболочке кишечника
Тип Plathelminthes Класс Cestoda Diphyllobothrium latum Размер зрелых проглоттид в ширину больше, чем в длину Они содержат открытую розетковидную матку
Тип Plathelminthes Класс Cestoda Diphyllobothrium latum Яйца широкоовальные (70 х45 мкм), желтовато- коричневого цвета с гладкой поверхностью На одном из полюсов имеется крышечка, на противоположном – бугорок
Тип Plathelminthes Половозрелые формы Класс Cestoda имеют длину 3 -5 мм Echinococcus granulosus Сколекс снабжен присосками и хоботком с двумя рядами крючьев Шейка короткая Стробила состоит из 3 -4 проглоттид Предпоследняя проглоттида гермафродитная, последняя – зрелая Матка у эхинококка – с боковыми выростами
Тип Nemathelminthes Класс Nematoda Ascaris suum На поперечном срезе видны кутикула, гиподерма, мускульные клетки, полость тела, каналы выделительной системы, нервные стволы, просвет кишечника, яичники, яйцеводы, и матка.
Тип Nemathelminthes Класс Nematoda Ascaris lumbricoides Яйца размером 50 -70 х40 -50 мкм Форма овальная, реже округлая Оболочка толстая, многослойная, бугристая, темно- желтая Внутри находится зародышевая клетка округлой формы или личинка в инвазионных яйцах
Тип Nemathelminthes Класс Nematoda Trichocephalus trichiurus Длина самки до 5 см Передний конец тела тонкий нитевидный, задний – утолщен В переднем отделе находится только пищевод, в заднем – все остальные органы
Тип Nemathelminthes Класс Nematoda Trichocephalus trichiurus Длина самца 4 -4, 5 см Передний конец тела тонкий нитевидный, задний – утолщен В переднем отделе находится только пищевод, в заднем – все остальные органы
Тип Nemathelminthes Класс Nematoda Trichocephalus trichiurus Размеры яйца 50 -55 х23 -32 мкм Форма лимонообразная
Тип Nemathelminthes Класс Nematoda Trichinella spiralis Личинки расположены в скелетной поперечнополосатой мышечной ткани Свернуты спиралью и покрыты соединительнотканной капсулой Размеры капсулы 0, 4 х 0, 25 мм
Тип Nemathelminthes Класс Nematoda Длина тела самки Enterobius vermicularis около 10 мм, белого цвета На переднем конце тела находится вздутия кутикулы – везикулы В задней части пищевода шарообразное расширение – бульбус, участвующие в фиксации паразита
Длина тела самца – 2 - Тип Nemathelminthes 5 мм Класс Nematoda Enterobius vermicularis Его задний конец тела закручен на брюшную сторону На переднем конце тела находится вздутие кутикулы – везикула В задней части пищевода шарообразное расширение – бульбус
Тип Nemathelminthes Класс Nematoda Enterobius vermicularis Размеры яиц 50 -60 х26 -30 мкм Форма овально- вытянутая, асимметричная (одна сторона выпуклая, другая
Тип Nemathelminthes Класс Nematoda Микрофилярии Wuchereria bancrofti (личинки) имеют размеры, около 30 мкм, извитой формы
Тип Nemathelminthes Класс Nematoda Ancylostoma duodenale Ротовая капсула Самка имеет длину 10 -13 мм, самец – 8 -10 мм Тело красноватого цвета На головном конце находится воронкообразная ротовая капсула с четырьмя кутикулярными зубцами
Тип Arthropoda Класс Arachnoidea Ротовой аппарат Отряд Аcari колюще-сосущего типа Семейство Ixodidae Он виден со спинной Самка клеща рода Ixodes стороны Есть глаза На спинной стороне тела есть хитиновый щиток, закрывающий только переднюю часть тела Это обеспечивает большую растяжимость брюшка при кровососании
Тип Arthropoda Ротовой аппарат Класс Arachnoidea (головка) колюще- Отряд Аcari сосущего типа виден Семейство Ixodidae со спинной стороны Самец клеща рода Dermacentor Есть глаза На спинной стороне тела самца расположен хитиновый щиток, который имеет эмалевый рисунок Он закрывает всю дорзальную поверхность клеща
Тип Arthropoda Класс Arachnoidea Отряд Аcari Размеры тела от 2 -х Семейство Argasidae до 30 -и мм Argas persicus Отсутствуют дорзальный щиток и глаза Ротовой аппарат расположен вентрально и не виден со спинной стороны Тело имеет краевой рант
Тип Arthropoda Класс Arachnoidea Отряд Аcari Семейство Tyroglyphidae Tyroglyphus farinae Клещи мелкие, 0, 4 -0, 7 мм Не имеют глаз Тело бледно-желтого цвета яйцевидной формы
Тип Arthropoda Класс Arachnoidea Отряд Аcari Семейство Sarcoptidae Sarcoptes scabiei Размеры 0, 3 -0, 4 мм Ноги укорочены, конической формы Тело широкоовальное, желтого цвета, покрыто щетинками Глаза отсутствуют
Тело сплющено с Тип Arthropoda боков, на Класс Insecta поверхности тела Отряд Aphaniptera есть Pulex irritans многочисленные волоски, щетинки, зубчики На голове расположены короткие усики и пара простых глаз Последняя пара ног длиннее остальных и служит для прыгания Ротовой аппарат колюще-сосущего типа
Тип Arthropoda Класс Insecta Длина тела Отряд Anoplura самца 2 -3 мм, Pediculus humanus capitis самки – 3 -4 мм Задний конец тела самца закруглен, у самки – раздвоен Ротовой аппарат колюще- сосущего типа
Тип Arthropoda Класс Insecta Отряд Anoplura Phthirus pubis Размеры до 1, 5 мм Тело короткое, широкое, трапециевидное Ротовой аппарат колюще-сосущего типа
Тип Arthropoda Класс Insecta Отряд Blattoidea Blattеlla germanica Ротовой аппарат грызущего типа: верхняя губа верхние челюсти нижняя губа нижние челюсти
Тип Arthropoda Класс Insecta Отряд Diptera Семейство Culicidae Род Culex Яйца имеют вытянутую клиновидную форму без воздушных камер
Тип Arthropoda Класс Insecta Отряд Diptera Семейство Culicidae Род Anopheles Яйца имеют поясок с воздушными камерами и плавают по одному
Тип Arthropoda Класс Insecta Отряд Diptera Семейство Culicidae Личинки имеют Род Culex голову грудь и брюшко На предпоследнем членике брюшка дыхательный сифон в виде узкой трубочки На конце сифона расположены стигмы
Тип Arthropoda Класс Insecta Отряд Diptera Семейство Culicidae Род Anopheles Личинки не имеют сифона Пара стигм, через которые они дышат атмосферным воздухом, располагается на предпоследнем членике брюшка
Тип Arthropoda Класс Insecta Куколки имеют форму Отряд Diptera запятой Семейство Culicidae На спинной стороне Род Culex головогруди находится пара дыхательных сифонов С их помощью куколки "подвешиваются" к поверхностной пленке воды Cифоны имеют цилиндрическую форму
Тип Arthropoda Класс Insecta Отряд Diptera Куколки имеют Семейство Culicidae форму запятой Род Anopheles На спинной стороне головогруди находится пара дыхательных сифонов Cифоны имеют воронкообразную (коническую) форму
Тип Arthropoda Класс Insecta Отряд Diptera Семейство Culicidae Род Culex Головки самцов имеют сильно опушенные усики Нижнечелюстные щупики обычно длиннее хоботка и на концах не имеют утолщений
Тип Arthropoda Класс Insecta Отряд Diptera Семейство Culicidae Род Anopheles Головки самцов имеют сильно опушенные усики Нижнечелюстные щупики по длине равны хоботку и имеют на конце булавовидные утолщения
Тип Arthropoda Класс Insecta Отряд Diptera Семейство Culicidae Род Culex Головки самок имеют слабо опушенные усики Нижнечелюстные щупики составляют 1/3 - 1/4 длины хоботка
Тип Arthropoda Класс Insecta Отряд Diptera Семейство Culicidae Род Anopheles Головки самок имеют слабо опушенные усики Нижнечелюстные щупики по длине равны хоботку

